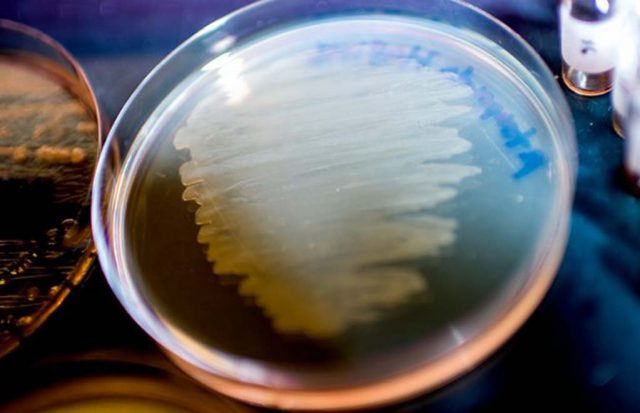
Antibiotik Superbug Ditemukan dari Sejenis Cacing

Sains
Mengungkap Gigitan Beracun Mamalia yang Selamat dari Hantaman Asteroid
Sekitar 66 juta tahun yang lalu, sebuah asteroid menabrak Bumi dan melenyapkan dinosaurus beserta tiga per empat kehidupan yang ada. Sisanya mungkin telah selamat dan salah satunya adalah sejenis mamalia pemakan serangga yang menyerupai tikus namun memiliki bisa yang berbahaya. Tim peneliti internasional memusatkan perhatian mereka pada spesies langka yang dikenal dengan Hispaniolan solenodon (Solenodon paradoxus) untuk mengungkap asal-usul racun yang dianggap tidak...
Antibiotik Superbug Ditemukan dari Sejenis Cacing
Para ilmuwan terus berupaya mencari cara untuk memerangi superbug, yaitu kuman yang kebal terhadap efek antibiotik, dan ini tidaklah mudah, karena semakin hari semakin banyak jenis bakteri dan jamur ditemukan yang kebal terhadap antibiotik, dan bisa saja suatu hari kita kehabisan amunisi untuk melawan superbug penyebab penyakit ini. Tetapi mungkin saja senjata baru untuk melawan superbug telah ditemukan, karena belum...
Bayi dalam Kandungan Lebih Dapat Melihat dari yang Diperkirakan
Jauh sebelum dapat melihat, bayi telah memiliki kemampuan dalam mendeteksi cahaya sejak dalam kandungan, menurut temuan terbaru para ilmuwan dari University of California, Berkeley. Meskipun demikian, sel-sel yang peka terhadap cahaya yang terdapat pada retina yang sedang dibentuk ini, dianggap sebagai sakelar on-off yang sederhana, mungkin untuk mengatur ritme 24 jam siang-malamnya orang tua dan berharap sang bayi akan mengikutinya. Para ilmuwan...
Blok Bangunan Kehidupan Ditemukan pada Meteorit oleh NASA
Sementara awal kehidupan diduga secara tunggal perlahan muncul pada sebuah genangan air di Bumi, namun sepertinya, prosesnya bisa dipercepat dengan kedatangan berbagai mereor yang membombardir Bumi dengan membawa serta senyawa kimia yang penting bagi terciptanya kehidupan. Sekarang, sebuah tim ilmuwan internasional telah menemukan berbagai senyawa gula yang tersimpan pada meteorit. Salah satu di antaranya adalah ribosa, komponen dari RNA yang digunakan...
Gula Rendah Kalori Berhasil di Sintesa Dengan Bantuan Bakteri
Bayangkan jika anda bisa mengkonsumsi gula tanpa perlu khawatir akan besarnya kalori yang masuk ke tubuh anda, gula yang hanya mengandung 38 persen dari kalori gula biasa, aman bagi penderita diabetes, dan juga bersahabat dengan gigi anda. Dan yang tidak kalah hebatnya, gula impian ini bukanlah garam pengganti buatan, tetapi benar-benar gula alami dengan rasa yang sama. Untuk anda...
Tiga Buah Lubang Hitam Supermasif Ditemukan di Pusat Sebuah Galaksi
Galaksi-galaksi yang berukuran besar seperti galaksi Bima Sakti biasanya terdiri dari ratusan milyar bintang dan menjadi tempat tinggal dari lubang hitam supermasif dengan besaran massa dari hanya beberapa juta hingga mencapai 100 juta kali massa matahari pada pusatnya. Hampir setiap galaksi di semesta yang pernah ditemukan mempunyai satu lubang hitam supermasif di pusatnya. Atau bisa kita katakan, setidaknya ada satu,...
Apakah Kita Penyebab Kepunahan Manusia Purba Lainnya?
Ada sembilan spesies manusia yang pernah menghuni planet Bumi 300,000 tahun yang lalu. Dan sekarang hanya tinggal tersisa satu spesies. Manusia Neanderthal, Homo neanderthalensis, ditemukan pertama kali di lembah Neanderthal, Jerman. Merupakan pemburu yang handal yang mampu berinovasi dan membuat teknologi baru untuk kehidupan sehari-hari mereka. Manusia Denisovan yang pernah menghuni benua Asia, dan yang lebih primitif adalah Homo erectus yang...
Apakah Kita Dalam Kepunahan Massal Ke-6
Selama lebih dari 3,5 milyar tahun, organisme hidup telah berevolusi, berkembang biak dan juga terdiversifikasi, untuk menjajah setiap ekosistem di permukaan bumi. Sisi lain dari ledakan spesies baru ini adalah proses kepunahan yang tidak bisa dihindarkan dan akan selalu menjadi bagian dari siklus evolusi kehidupan. Dan ternyata kedua proses ini tidak selalu sejalan. Seharusnya, ketika terjadinya kepunahan spesies secara sangat...
Ada Sejenis Serangga dan Reptil di Mars, Klaim Seorang Entomolog
Berbagai temuan terakhir di Mars semakin mendorong untuk diluncurkannya sebuah misi selanjutnya oleh NASA untuk mengeksplorasi lebih jauh terkait bukti adanya kehidupan, meski dalam kelas mikroba. Namun, serorang ilmuwan menunjukkan bahwa sebenarnya kehidupan telah ditemukan di planet merah, dan itu melebihi sekadar mahluk-mahluk kecil, menurutnya ada bukti yang menunjukkan sejenis serangga di sana. William Romoser, seorang ahli entomologi dari Ohio University,...
Berapa Umur Anjing Anda Bila Dikonversikan ke Umur Manusia
Tidak ada yang tahu bagaimana asal mulanya, atau darimana asalnya, ide yang menyebutkan bahwa kita bisa mengkonversi usia manusia dengan anjing dengan mengkalikannya dengan bilangan tujuh? Bisa dibilang bahwa teori itu hanyalah mitos belaka. Tetapi, jika kita hanya ingin mengkontekstualisasikan seberapa tua hewan peliharaan jika dibandingkan dengan lamanya hidup kita; bukan hal lain, teori diatas bisa digunakan. Untuk menemukan cara...